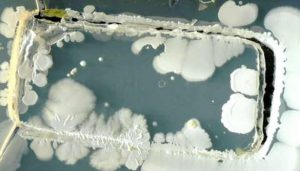

நம் கையில் எந்நேரமும் தவழ்ந்து கொண்டிருக்கும் ஸ்மார்ட்போன்கள் பல்வேறு பாதிப்புகளை ஏற்படுத்துவதாக தகவல்கள் வெளியாகி வந்த நிலையில் ஸ்மார்ட்போன்களில் 3 புதிய நுண்ணுயிர் கிருமிகள் வாழ்வது தெரியவந்துள்ளது.
நம் கையில் எந்நேரமும் தவழ்ந்து கொண்டிருக்கும் ஸ்மார்ட்போன்கள் பல்வேறு பாதிப்புகளை ஏற்படுத்துவதாக தகவல்கள் வெளியாகி வந்த நிலையில் ஸ்மார்ட்போன்களில் 3 புதிய நுண்ணுயிர் கிருமிகள் வாழ்வது தெரியவந்துள்ளது.
நாம் அன்றாடம் கையில் வைத்து பயன்படுத்தி வரும் ஸ்மார்ட்போன்களில் மூன்று விதமான புதிய நுண்ணுயிர் கிருமிகள் உயிர் வாழ்வதை ஆராய்ச்சியாளர்கள் கண்டுபிடித்துள்ளனர். மேற்கத்திய நாடுகளில் இதுவரை மேற்கொள்ளப்பட்டுள்ள பல்வேறு ஆய்வுகளில் நாம் பயன்படுத்தி வரும் ஸ்மார்ட்போன்களில் அதிகப்படியான கிருமிகள் மற்றும் பாக்டீரியா உள்ளிட்டவை இருப்பதாக தெரிவிக்கப்பட்டது.
கழிவறைகளில் காணப்படுவதை விட பலமடங்கு பாக்டீரியா மற்றும் கிருமிகள் உள்ளதாக ஆய்வில் தெரியவந்துள்ளது. கழிவறைகளில் வழக்கமாக இரண்டு அல்லது மூன்று வகையான கிருமிகள் மட்டுமே இருக்கும் ஆனால் ஸ்மார்ட்போன்களில் சராசரியாக 10-12 வகையான கிருமிகள் இருப்பது முன்னதாக மேற்கொள்ளப்பட்ட ஆய்வுகளில் கண்டுபிடிக்கப்பட்டது. இவற்றில் சில கிருமிகளை எவ்வித கிருமி நாசினிகளாலும் அழிக்க முடியாது என்பதும் குறிப்பிடத்தக்கது.
இந்நிலையில் மத்திய அரசின் தேசிய செல் அறிவியல் மையத்தின் ஆராய்ச்சியாளர்கள் மேற்கொண்ட ஆய்வில் ஸ்மார்ட்போன் திரையில் மூன்று விதமான புதிய நுண்ணுயிர் கிருமிகள் இருப்பது கண்டுபிடிக்கப்பட்டுள்ளது. அறிவியல் இலக்கியத்தில் இதுவரை இல்லாத இரண்டு வித பாக்டீரியா மற்றும் பூஞ்சை (ஃபங்கஸ்) இருப்பது பயோடெக்னாலஜி துறையினரால் கண்டுபிடிக்கப்பட்டுள்ளது.

இந்தியாவை பொருத்த வரை நிலைமை இன்னும் கட்டுக்குள் இருக்கும் போதும், வாடிக்கையாளர்கள் இது போன்ற கிருமிகளில் இருந்து பாதிக்கப்படாமல் இருக்க ஸ்மார்ட்போன் திரைகளை அவ்வப்போது மெல்லிய துணியை கொண்டு சுத்தம் செய்வது நல்லது என கூறப்படுகிறது. எனினும் ஸ்மார்ட்போன்களை சுத்தம் செய்யும் போது அவற்றை ஆஃப் செய்து வைக்க வேண்டும் என பரிந்துரைக்கப்படுகிறது.
மேற்கண்ட தகவல்கள் பிரபல செய்தி நிறுவனமான பிடிஐக்கு அறிவியல் ஆய்வாளர் பல்லவி பாக்லா வெளியிட்ட கட்டுரை தொகுப்பில் தெரிவிக்கப்பட்டுள்ளது.















